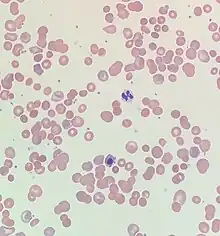

| Drug-induced autoimmune heamolytic anemia | |
|---|---|
| Other names | Drug-induced immune hemolytic anemia, DIIHA. |
| |
| Blood smear from a patient with warm autoimmune hemolytic anemia showing spherocytes, marked polychromasia and a nucleated red blood cell. | |
| Specialty | Hematology |
| Symptoms | Fatigue, shortness of breath, dizziness, bloody urine, jaundice, weakness, and palpitations[1] |
| Complications | Hemolysis, shock, ischemia, acute respiratory distress syndrome, disseminated intravascular coagulation,[1] and acute renal failure.[2] |
| Usual onset | Hours to months of the initial drug exposure.[1] |
| Causes | Antimicrobials, nonsteroidal anti-inflammatory drugs, antineoplastic drugs, and other drugs.[3] |
| Diagnostic method | Blood tests, blood smear, and Direct antiglobulin testing[4] |
| Differential diagnosis | Warm antibody autoimmune hemolytic anemia.[4] |
| Treatment | Stopping the offending drug, blood transfusions, and thromboprophylaxis.[4] |
| Frequency | One to two people per million worldwide.[1] |
Drug-induced autoimmune hemolytic anemia also known as Drug-induced immune hemolytic anemia (DIIHA) is a rare cause of hemolytic anemia. It is difficult to differentiate from other forms of anemia which can lead to delays in diagnosis and treatment. Many different types of antibiotics can cause DIIHA and discontinuing the offending medication is the first line of treatment. DIIHA has is estimated to affect one to two people per million worldwide.[1]
In some cases, a drug can cause the immune system to mistakenly think the body's own red blood cells are dangerous, foreign substances. Antibodies then develop against the red blood cells. The antibodies attach to red blood cells and cause them to break down too early. It is known that more than 150 drugs can cause this type of hemolytic anemia.[5] The list includes:
- Cephalosporins (a class of antibiotics)
- Dapsone
- Levodopa
- Levofloxacin
- Methyldopa
- Nitrofurantoin
- Nonsteroidal anti-inflammatory drugs (NSAIDs) - among them, the commonly used Diclofenac and Ibuprofen
- Phenazopyridine (pyridium)
- Quinidine[6]
Signs and symptoms
Initial symptoms of drug-induced autoimmune hemolytic anemia are typically vague and reflect mild, moderate, or severe anemia. Symptoms of DIIHA can manifest within hours to months of the initial drug exposure.[1] DIIHA ranges in severity from severe intravascular hemolysis to milder presentations of extravascular hemolysis.[7] Common symptoms of DIIHA are fatigue, shortness of breath, dizziness, bloody or dark urine,[1] weakness, and palpitations. DIIHA will occasionally present as hemoglobinuria with chills, however this is quite rare.[2] Patients with DIIHA may appear pale and have jaundice. Hepatomegaly, splenomegaly, and adenopathy have also been observed.[1]
When DIIHA is not recognized promptly it can have life-threatening complications such as hemolysis leading to shock, ischemia, acute respiratory distress syndrome, disseminated intravascular coagulation,[1] and acute renal failure.[2]
Causes
As of 2020 over 130 drugs have been reported to cause DIIHA. That number will continue to rise as new drugs are discovered.[1] Antimicrobials are responsible for 42% of DIIHA cases, making them the most common cause. Nonsteroid anti-inflammatory drugs cause about 15% of cases and antineoplastic drugs cause around 11%.[3]
Mechanism
The main mechanism of DIIHA is the development of antibodies. Drug-induced antibodies can be classified into two groups, drug-dependent antibodies and drug-independent autoantibodies. Drug-dependent antibodies are common in DIIHA. They require the offending drug to be present in order to bind and lyse cells.[8]
Drug-independent autoantibodies are a less common factor in DIIHA. Drug-independent autoantibodies are found in Drug-induced autoimmune hemolytic anemia because of beta-lactamase inhibitors and platinum-based chemotherapeutics. These autoantibodies can sometimes bind and react to red blood cells even in the absence of whatever drug triggered the anemia.[8]
Diagnosis
Drug-induced autoimmune hemolytic anemia causes a significant drop in hemoglobin and hematocrit. Occasionally DIIHA can present with mild leukocytosis. In it's earlier stages patients with DIIHA will have low reticulocytes. As HIIHA progresses reticulocytes increase leading to an elevated mean corpuscular volume. Indirect bilirubin and Lactate dehydrogenase become elevated. LFTs occasionally become elevated. In some cases, a peripheral blood smear may show schistocytes, anisocytosis, polychromasia, or poikilocytosis.[7]
Direct antiglobulin testing is the only way to confirm DIIHA. Direct antiglobulin testing can determine if complement C3 antibody and/or immunoglobulin G is bound to the red blood cell membrane.[4] A positive direct antiglobulin test differentiates immune-mediated hemolytic anemia from a nonimmune-mediated cause. Other situations such as liver disease, post-transfusion or immunoglobulin administration, renal disease, and malignancy can cause a positive direct antiglobulin test.[1] If both complement C3 Antibodies and immunoglobulin G are positive or if only immunoglobulin G is positive then warm antibody autoimmune hemolytic anemia must be considered as a differential diagnosis.[4]
Treatment
An appropriate course of treatment for drug-induced autoimmune hemolytic anemia hasn't yet been established. Once DIIHA has been recognized, the patient must stop whatever drug caused the anemia in order to provide proper treatment. Patients should be given blood transfusions as needed. The use of thromboprophylaxis is encouraged because despite being anemic, patients are often hypercoagulable.[4] Although corticosteroids have been used to treat DIIHA it is difficult to differentiate how much effects corticosteroids actually have on DIIHA.[9]
If drug-independent autoantibodies are involved and stopping the offending agents results in no response then intravenous immunoglobulins and immunosuppressants such as rituximab, azathioprine, cyclophosphamide, cyclosporine, danazol, and mycophenolate can be used.[8][10] Improvement is typically seen within a few weeks of cessation of the offending drug.[1]
See also
References
- 1 2 3 4 5 6 7 8 9 10 11 12 Chan Gomez, Janet; Saleem, Tabinda; Snyder, Samantha; Joseph, Maria; Kanderi, Tejaswi (June 17, 2020). "Drug-Induced Immune Hemolytic Anemia due to Amoxicillin-Clavulanate: A Case Report and Review". Cureus. Cureus, Inc. 12 (6): e8666. doi:10.7759/cureus.8666. ISSN 2168-8184. PMC 7370667. PMID 32699666.
- 1 2 3 Chen, Fei; Zhan, Zhuying (2014). "Severe drug-induced immune haemolytic anaemia due to ceftazidime". Blood Transfusion. Edizioni SIMTI. 12 (3): 435–437. doi:10.2450/2014.0237-13. PMC 4111830. PMID 24887228.
- 1 2 Garratty, George (January 1, 2009). "Drug-induced immune hemolytic anemia". Hematology. American Society of Hematology. 2009 (1): 73–79. doi:10.1182/asheducation-2009.1.73. ISSN 1520-4391. Retrieved November 21, 2023.
- 1 2 3 4 5 6 Hill, Quentin A.; Stamps, Robert; Massey, Edwin; Grainger, John D.; Provan, Drew; Hill, Anita (2017). "Guidelines on the management of drug-induced immune and secondary autoimmune, haemolytic anaemia". British Journal of Haematology. Wiley. 177 (2): 208–220. doi:10.1111/bjh.14654. ISSN 0007-1048.
- ↑ Barcellini, Wilma (2015-10-01). "Immune Hemolysis: Diagnosis and Treatment Recommendations". Seminars in Hematology. Anemia in Clinical Practice. 52 (4): 304–312. doi:10.1053/j.seminhematol.2015.05.001. ISSN 0037-1963. PMID 26404442.
- ↑ MedlinePlus Encyclopedia: Drug-induced immune hemolytic anemia
- 1 2 Karunathilaka, H. G. C. S.; Chandrasiri, D. P.; Ranasinghe, P.; Ratnamalala, V.; Fernando, A. H. N. (March 31, 2020). "Co-Amoxiclav Induced Immune Haemolytic Anaemia: A Case Report". Case Reports in Hematology. Hindawi Limited. 2020: 1–3. doi:10.1155/2020/9841097. ISSN 2090-6560. PMC 7150724. PMID 32292611.
- 1 2 3 Leicht, Hans Benno; Weinig, Elke; Mayer, Beate; Viebahn, Johannes; Geier, Andreas; Rau, Monika (October 25, 2018). "Ceftriaxone-induced hemolytic anemia with severe renal failure: a case report and review of literature". BMC Pharmacology and Toxicology. Springer Science and Business Media LLC. 19 (1): 67. doi:10.1186/s40360-018-0257-7. ISSN 2050-6511. PMC 6203207. PMID 30359322.
- ↑ Garbe, Edeltraut; Andersohn, Frank; Bronder, Elisabeth; Klimpel, Andreas; Thomae, Michael; Schrezenmeier, Hubert; Hildebrandt, Martin; Späth-Schwalbe, Ernst; Grüneisen, Andreas; Mayer, Beate; Salama, Abdulgabar; Kurtal, Hanife (July 12, 2011). "Drug induced immune haemolytic anaemia in the Berlin Case-Control Surveillance Study". British Journal of Haematology. Wiley. 154 (5): 644–653. doi:10.1111/j.1365-2141.2011.08784.x. ISSN 0007-1048. PMID 21749359.
- ↑ Wu, Yuanjun; Wu, Yong; Ji, Yanli; Liang, Jiajie; He, Ziyi; Liu, Yanhui; Tang, Li; Guo, Ganping (August 12, 2021). "Case Report: Drug-Induced Immune Haemolytic Anaemia Caused by Cefoperazone-Tazobactam/ Sulbactam Combination Therapy". Frontiers in Medicine. Frontiers Media SA. 8. doi:10.3389/fmed.2021.697192. ISSN 2296-858X. PMC 8415779. PMID 34485334.
Further reading
- Chan, Maverick; Silverstein, William K.; Nikonova, Anna; Pavenski, Katerina; Hicks, Lisa K. (April 28, 2020). "Bendamustine-induced immune hemolytic anemia: a case report and systematic review of the literature". Blood Advances. American Society of Hematology. 4 (8): 1756–1759. doi:10.1182/bloodadvances.2020001726. ISSN 2473-9529. PMC 7189296. PMID 32343794.
- Mayer, Beate; Bartolmäs, Thilo; Yürek, Salih; Salama, Abdulgabar (2015). "Variability of Findings in Drug-Induced Immune Haemolytic Anaemia: Experience over 20 Years in a Single Centre". Transfusion Medicine and Hemotherapy. S. Karger AG. 42 (5): 333–339. doi:10.1159/000440673. ISSN 1660-3796. PMC 4678312. PMID 26696803.
- Salama, Abdulgabar (2009). "Drug-induced immune hemolytic anemia". Expert Opinion on Drug Safety. Informa UK Limited. 8 (1): 73–79. doi:10.1517/14740330802577351. ISSN 1474-0338. S2CID 263607634. Retrieved November 21, 2023.